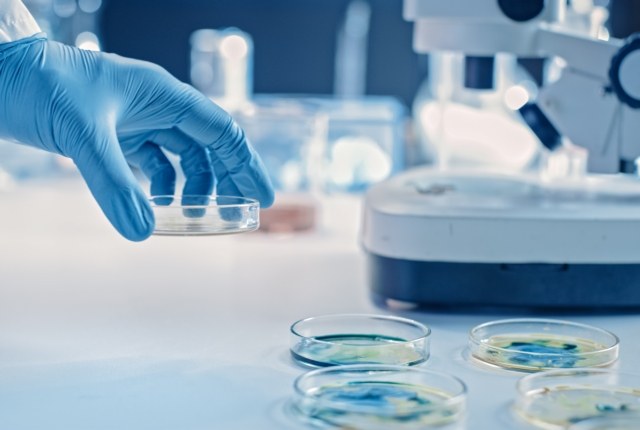

Prima di manifestarsi in pieno, il mieloma multiplo - un tumore maligno che colpisce un tipo particolare di cellule del midollo osseo, le plasmacellule - è preceduto dallo sviluppo di forme precoci e asintomatiche della malattia. Analizzando il genoma di oltre mille pazienti, un gruppo internazionale di studiosi è riuscito a mettere a punto uno strumento per valutare i segnali di pericolo e il rischio di sviluppare la forma tumorale. I risultati sono stati pubblicati su Nature Genetics.
"Fino a oggi non avevamo uno strumento genomico affidabile e di facile utilizzo per capire, sin dall’inizio, chi tra coloro che presentano forme precoci e asintomatiche della malattia corre davvero il rischio di sviluppare un mieloma multiplo", spiega Andrea Poletti, ricercatore al Dipartimento di Scienze Mediche e Chirurgiche dell'Università di Bologna, tra gli autori dello studio. "L'analisi che abbiamo realizzato colma questa lacuna: offre una bussola genetica capace di orientare i medici fin dalle fasi più precoci della malattia ed eventualmente fornire un chiaro segnale di allerta clinica".
Sono due le forme precursori silenziose del mieloma multiplo: una è chiamata "gammopatia monoclonale di significato incerto" (MGUS) e l'altra "mieloma multiplo latente" (SMM). Solo una parte dei pazienti che sviluppa queste forme precoci arriva però alla malattia. Gli studiosi si sono quindi concentrati sulla ricerca dei fattori genetici che possono indicare il rischio di questa progressione maligna.
Per farlo, hanno analizzato il DNA di 1.030 campioni tumorali prelevati da pazienti con mieloma multiplo, sequenziando l'intero genoma e mettendo in evidenza non solo le mutazioni più note, ma anche diversi altri tipi di alterazioni molecolari. Per garantire che i risultati fossero affidabili, l'analisi è stata fatta su due coorti indipendenti di pazienti e su diversi campioni prelevati dagli stessi pazienti nell’arco di oltre quattro anni.
A partire da 17 alterazioni genomiche chiave, gli studiosi hanno ideato un nuovo punteggio con una scala da 0 a 12, chiamato "MM like score". Grazie a questo nuovo strumento è possibile definire chiaramente se il paziente è affetto da una delle forme precursori o da mieloma multiplo.
"Abbiamo visto che i pazienti con uno score superiore a 1 raddoppiano o in alcuni casi addirittura triplicano il rischio che una forma di mieloma multiplo latente diventi mieloma multiplo, offrendo così un chiaro segnale di allerta clinica", dice Elena Zamagni, professoressa al Dipartimento di Scienze Mediche e Chirurgiche, che ha partecipato allo studio. “Inoltre, la nostra indagine ha messo in luce una progressione 'a scaletta' della malattia, in cui eventi genetici tardivi come alterazioni di specifici geni, delezioni di cromosomi o mutazioni di pathway, fungono da acceleratori della progressione maligna della malattia".
I risultati ottenuti hanno evidenziato anche che il percorso di sviluppo della malattia può essere molto lungo, con la prima "scintilla genetica" del mieloma che nasce in media tra 20 e 30 anni prima della diagnosi.
Il nuovo sistema di valutazione potrebbe permettere quindi di selezionare pazienti con mieloma multiplo latente che sono ad alto rischio, con il vantaggio di poter ripetere il test più volte senza la necessità di prelevare campioni di midollo osseo. A questo si aggiunge poi l'individuazione di nuovi elementi genetici e mutazioni chiave che possono essere utilizzati per mettere a punto terapie mirate, da sperimentare già nei pazienti con forme precoci e asintomatiche di mieloma multiplo.
Lo studio è stato pubblicato su Nature Genetics con il titolo “Genomic landscape of multiple myeloma and its precursor conditions”. Per l’Università di Bologna hanno collaborato Andrea Poletti, Carolina Terragna e Elena Zamagni del Dipartimento di Scienze Mediche e Chirurgiche.